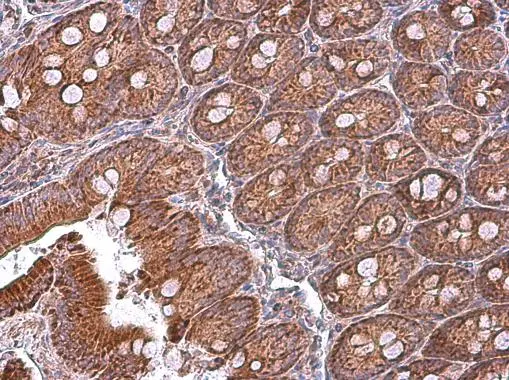
MFN1 antibody detects MFN1 protein at cytoplasm in rat duodenum by immunohistochemical analysis. Sample: Paraffin-embedded rat duodenum. MFN1 antibody (GTX133351) diluted at 1:500. 
 Antigen Retrieval: Citrate buffer, pH 6.0, 15 min

Rat tissue extract (50 μg) was separated by 7.5% SDS-PAGE, and the membrane was blotted with MFN1 antibody (GTX133351) diluted at 1:1000. The HRP-conjugated anti-rabbit IgG antibody (GTX213110-01) was used to detect the primary antibody.
MFN1 antibody
GTX133351
ApplicationsWestern Blot, ImmunoHistoChemistry, ImmunoHistoChemistry Paraffin
Product group Antibodies
ReactivityHuman, Mouse, Rat
TargetMfn1
Overview
- SupplierGeneTex
- Product NameMFN1 antibody
- Delivery Days Customer9
- Application Supplier NoteWB: 1:500-1:3000. IHC-P: 1:100-1:1000. *Optimal dilutions/concentrations should be determined by the researcher.Not tested in other applications.
- ApplicationsWestern Blot, ImmunoHistoChemistry, ImmunoHistoChemistry Paraffin
- CertificationResearch Use Only
- ClonalityPolyclonal
- Concentration0.54 mg/ml
- ConjugateUnconjugated
- Gene ID67414
- Target nameMfn1
- Target descriptionmitofusin 1
- Target synonyms2310002F04Rik, 6330416C07Rik, D3Ertd265e, HR2, mKIAA4032, mitofusin-1, transmembrane GTPase MFN1
- HostRabbit
- IsotypeIgG
- Protein IDQ811U4
- Protein NameMitofusin-1
- Scientific DescriptionEssential transmembrane GTPase, which mediates mitochondrial fusion. Fusion of mitochondria occurs in many cell types and constitutes an important step in mitochondria morphology, which is balanced between fusion and fission. MFN1 acts independently of the cytoskeleton. Overexpression induces the formation of mitochondrial networks.
- ReactivityHuman, Mouse, Rat
- Storage Instruction-20°C or -80°C,2°C to 8°C
- UNSPSC12352203
References
- Chen KC, Chen CR, Chen CY, et al. Bicalutamide Exhibits Potential to Damage Kidney via Destroying Complex I and Affecting Mitochondrial Dynamics. J Clin Med. 2021,11(1). doi: 10.3390/jcm11010135Read this paper
- Li CJ, Lin LT, Tsai HW, et al. Phosphoglycerate mutase family member 5 maintains oocyte quality via mitochondrial dynamic rearrangement during aging. Aging Cell. 2022,21(2):e13546. doi: 10.1111/acel.13546Read this paper
- Yan H, Zhao H, Kang Y, et al. Parecoxib alleviates the motor behavioral decline of aged rats by ameliorating mitochondrial dysfunction in the substantia nigra via COX-2/PGE2 pathway inhibition. Neuropharmacology. 2021,194:108627. doi: 10.1016/j.neuropharm.2021.108627Read this paper
- Sakiyama H, Li L, Kuwahara-Otani S, et al. A lack of ChREBP inhibits mitochondrial cristae formation in brown adipose tissue. Mol Cell Biochem. 2021,476(10):3577-3590. doi: 10.1007/s11010-021-04178-2Read this paper
- Ding M, Liu C, Shi R, et al. Mitochondrial fusion promoter restores mitochondrial dynamics balance and ameliorates diabetic cardiomyopathy in an optic atrophy 1-dependent way. Acta Physiol (Oxf). 2020,229(1):e13428. doi: 10.1111/apha.13428Read this paper